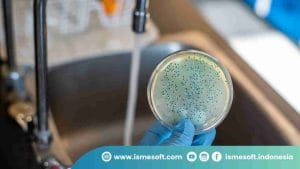
Cara Mencegah Cross Contamination

Ismesoft — Apa Itu Cross Contamination? Cross contamination adalah ancaman tersembunyi yang mengintai di dapur kita. Perpindahan bakteri, virus, atau parasit dari makanan mentah ke makanan matang dapat menyebabkan berbagai penyakit serius. Dalam artikel ini, kita akan membahas secara mendalam apa itu cross contamination, bagaimana hal itu terjadi, dan yang terpenting, bagaimana cara mencegahnya.
Daftar Isi
ToggleApa Itu Cross Contamination?

Cross contamination adalah proses perpindahan bakteri berbahaya dari makanan mentah atau permukaan yang terkontaminasi ke makanan siap saji. Misalnya, ketika Anda memotong ayam mentah di atas talenan, lalu menggunakan talenan yang sama untuk memotong sayuran tanpa mencucinya terlebih dahulu, bakteri dari ayam mentah dapat berpindah ke sayuran. Hal ini dapat menyebabkan keracunan makanan jika sayuran tersebut dikonsumsi tanpa dimasak dengan benar.
Bagaimana Cross Contamination Terjadi?

Kontaminasi silang bisa terjadi melalui berbagai cara, baik di dapur rumah, restoran, atau industri makanan. Berikut adalah beberapa cara umum terjadinya:
Peralatan Dapur:
- Talenan: Menggunakan talenan yang sama untuk memotong daging mentah dan sayuran tanpa mencucinya terlebih dahulu.
- Pisau: Pisau yang digunakan untuk memotong daging mentah dapat menjadi sarang bakteri jika tidak dibersihkan dengan benar sebelum digunakan untuk memotong makanan lain.
- Wadah: Menggunakan wadah yang sama untuk menyimpan makanan mentah dan matang tanpa mencucinya.
Tangan:
- Tidak mencuci tangan: Menyentuh makanan matang dengan tangan yang telah menyentuh daging mentah, unggas, atau makanan laut tanpa mencuci tangan dengan sabun dan air mengalir.
- Menjilati jari: Kebiasaan menjilati jari saat memasak dapat memindahkan bakteri dari mulut ke makanan.
Permukaan:
- Daging mentah menetes: Tetesan cairan dari daging mentah yang menetes ke permukaan meja atau piring dapat mengkontaminasi makanan lain.
- Sayuran yang tidak dicuci: Sayuran yang tidak dicuci dengan bersih dapat membawa bakteri dari tanah atau air yang digunakan untuk menyiramnya.
Udara:
- Partikel makanan: Partikel kecil dari makanan mentah dapat terbawa oleh udara dan menempel pada makanan matang.
- Batuk atau bersin: Orang yang sakit dapat menyebarkan bakteri melalui batuk atau bersin ke makanan.
Orang:
- Pakaian: Pakaian yang terkontaminasi oleh makanan mentah dapat menjadi sumber penyebaran bakteri.
- Rambut: Rambut yang tidak tertutup dapat menjadi tempat menempelnya bakteri dan kemudian jatuh ke makanan.
Contoh Kasus Nyata
- Daging mentah dipotong di atas talenan.
- Bakteri dari daging mentah menempel pada talenan.
- Talenan digunakan untuk memotong sayuran. Bakteri berpindah ke sayuran.
- Sayuran yang terkontaminasi dikonsumsi dan menyebabkan keracunan makanan.
Dengan penjelasan yang detail dan contoh-contoh yang relevan, pembaca akan lebih memahami betapa mudahnya cross contamination terjadi dan betapa pentingnya mencegahnya.
Bahaya Cross Contamination

Kontaminasi silang merupakan ancaman serius bagi kesehatan manusia. Jika makanan yang telah terkontaminasi dikonsumsi, dapat menyebabkan berbagai penyakit, mulai dari gangguan pencernaan ringan hingga infeksi serius. Beberapa bahaya yang dapat ditimbulkan oleh cross contamination antara lain:
- Keracunan Makanan: Ini adalah salah satu akibat paling umum dari cross contamination. Gejala keracunan makanan bisa bervariasi, mulai dari mual, muntah, diare, sakit perut, demam, hingga dehidrasi.
- Infeksi: Beberapa bakteri atau virus yang menyebabkan kontaminasi silang dapat menyebabkan infeksi serius, seperti infeksi saluran pencernaan, infeksi saluran kemih, bahkan sepsis (infeksi seluruh tubuh).
- Penyakit Jangka Panjang: Pada beberapa kasus, infeksi akibat kontaminasi silang dapat menyebabkan komplikasi jangka panjang, seperti sindrom hemolitik uremik (HUS) yang terutama menyerang anak-anak.
- Kematian: Meskipun jarang terjadi, dalam kasus yang parah, keracunan makanan akibat cross contamination dapat menyebabkan kematian, terutama pada kelompok rentan seperti bayi, lansia, dan orang dengan sistem kekebalan tubuh yang lemah.
Bakteri Penyebab Cross Contamination
Beberapa jenis bakteri yang sering menyebabkan kontaminasi silang dan menimbulkan masalah kesehatan antara lain:
- Salmonella: Umum ditemukan pada unggas, telur, dan daging mentah.
- E. coli: Sering ditemukan pada daging sapi mentah, terutama pada bagian usus.
- Listeria: Bakteri ini dapat tumbuh pada suhu dingin dan sering ditemukan pada makanan siap saji seperti keju lunak dan sayuran siap makan.
- Campylobacter: Umum ditemukan pada unggas mentah.
Kelompok Rentan
Beberapa kelompok orang lebih rentan terhadap dampak buruk dari cross contamination, antara lain:
- Bayi dan anak-anak: Sistem kekebalan tubuh mereka belum sepenuhnya berkembang, sehingga lebih mudah terinfeksi.
- Lansia: Sistem kekebalan tubuh mereka cenderung melemah seiring bertambahnya usia.
- Wanita hamil: Infeksi selama kehamilan dapat berdampak pada kesehatan ibu dan janin.
- Orang dengan sistem kekebalan tubuh lemah: Orang dengan kondisi medis tertentu, seperti HIV/AIDS atau yang sedang menjalani kemoterapi, memiliki risiko lebih tinggi terkena infeksi.
Untuk menghindari bahaya yang ditimbulkan oleh cross contamination, sangat penting untuk menerapkan praktik kebersihan yang baik saat mengolah makanan.
Cara Mencegah Cross Contamination
Untuk melindungi diri Anda dan keluarga dari risiko keracunan makanan akibat cross contamination, berikut adalah beberapa langkah pencegahan yang dapat Anda lakukan:
1. Pisahkan Makanan Mentah dan Matang
- Talenan dan Peralatan: Gunakan talenan dan peralatan yang berbeda untuk memotong daging mentah, unggas, dan seafood. Cuci bersih peralatan tersebut dengan sabun dan air panas setelah digunakan.
- Wadah Penyimpanan: Simpan makanan mentah dan matang dalam wadah yang terpisah di lemari es.
2. Cuci Tangan dengan Rutin
- Sebelum dan Sesudah: Cuci tangan dengan sabun dan air mengalir selama minimal 20 detik sebelum dan sesudah mengolah makanan, terutama setelah menyentuh daging mentah.
- Gunakan Hand Sanitizer: Jika tidak ada air dan sabun, gunakan hand sanitizer yang mengandung setidaknya 60% alkohol.
3. Masak Makanan Sampai Matang Sempurna
- Suhu yang Tepat: Gunakan termometer makanan untuk memastikan daging, unggas, dan seafood dimasak pada suhu yang tepat untuk membunuh bakteri.
- Tidak Setengah Matang: Hindari mengonsumsi makanan yang masih setengah matang, terutama daging.
4. Bersihkan Permukaan Dapur
- Desinfektan: Setelah mengolah makanan mentah, bersihkan semua permukaan dapur, termasuk talenan, wastafel, dan kompor dengan disinfektan atau larutan pemutih.
- Spons: Ganti spons secara teratur karena dapat menjadi sarang bakteri.
5. Simpan Makanan dengan Benar
- Suhu Lemari Es: Atur suhu lemari es pada 4°C atau lebih rendah untuk menghambat pertumbuhan bakteri.
- Wadah Tertutup: Simpan makanan dalam wadah tertutup untuk mencegah kontaminasi silang dengan makanan lain.
6. Hindari Mencicipi Makanan dengan Alat yang Sama
- Sendok dan Garpu: Jangan menggunakan sendok atau garpu yang sama untuk mencicipi makanan mentah dan matang.
7. Jaga Kebersihan Diri
- Rambut: Gunakan penutup kepala saat memasak untuk mencegah rambut jatuh ke makanan.
- Pakaian: Ganti pakaian yang terkena percikan makanan mentah sebelum mengolah makanan lain.
8. Lindungi Makanan dari Serangga dan Hewan Peliharaan
- Tutup Makanan: Tutup makanan dengan rapat untuk mencegah serangga atau hewan peliharaan mengaksesnya.
Dengan menerapkan langkah-langkah pencegahan di atas, Anda dapat secara efektif mengurangi risiko terjadinya cross contamination dan menjaga keamanan pangan di rumah Anda.
Tips Tambahan:
- Pendidikan: Ajarkan anggota keluarga, terutama anak-anak, tentang pentingnya kebersihan makanan dan cara mencegah cross contamination.
- Periksa Kemasan: Sebelum membeli makanan siap saji, periksa tanggal kedaluwarsa dan kondisi kemasannya.
- Cuci Buah dan Sayuran: Cuci buah dan sayuran dengan air mengalir sebelum mengonsumsinya, meskipun akan dimasak.
Dengan menjaga kebersihan dan menerapkan praktik penanganan makanan yang baik, Anda dapat melindungi diri sendiri dan keluarga dari penyakit yang disebabkan oleh kontaminasi silang.
Kesimpulan
Mencegah cross contamination adalah kunci untuk menjaga kesehatan keluarga. Dengan menerapkan langkah-langkah sederhana seperti memisahkan makanan mentah dan matang, mencuci tangan secara teratur, dan memasak makanan hingga matang sempurna, Anda dapat melindungi diri dari risiko keracunan makanan. Ingat, kebiasaan baik dalam mengolah makanan adalah investasi untuk kesehatan yang lebih baik.
Ismesoft
Untuk sobat yang baru merintis usaha baru, jangan takut karena Ismesoft siap membantu kawan entrepeneur semua untuk dapat mencari peluang dalam mengembangkan bisnis atau usaha dengan cara memberikan bantuan berupa asisten akuntansi digital yang praktis dan fungsional. Kawan entrepeneur dapat menghubungi kontak yang tertera pada website ini jika ingin mengetahui lebih lanjut tentang produk unggulan kami. Terus nantikan kabar terbaru lainnya dari Ismesoft. Bagi kawan entrepeneur yang telah bekerja sama dengan Ismesoft, yuk tulis pengalaman yang kawan rasakan di kolom komentar ya. Nantikan terus tips, tutorial dan konten Ismesoft lainya yaa. Cuma di Ismesoft anda bisa menikmati kemudahan dalam mengatur keuangan tanpa repot menghitung! Cek website kami di Ismesoft.com

